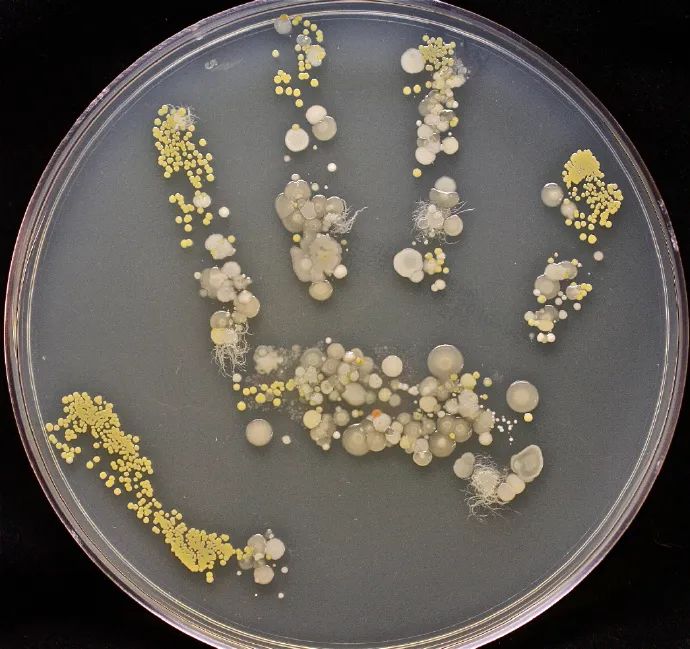
据塔莎描述,她先是将印了手印的培养皿放进温度为37摄氏度的恒温箱里

手部细菌培养

科学家们会利用培养皿和培养基来培养微生物.
图片尺寸800x600
洗手过后,再次用细菌培养平皿采集小朋友们的干净手印.
图片尺寸1079x1447
小班健康课《手上的病菌》培养幼儿良好的 - 抖音
图片尺寸1080x1906
【作品交流】细菌宝宝成长记_培养皿
图片尺寸1080x556
生动形象的讲解了手上细菌培养的过程,让同学真正感受到细菌的真实
图片尺寸1334x996
实验了洗手前和洗手后的手部卫生区别下面是小组成员的手部细菌培养皿
图片尺寸750x1000
为什么进家门第一件事是洗手?看了这些你就全懂了!
图片尺寸560x448
洗手液组培养48小时
图片尺寸1080x810
据塔莎描述,她先是将印了手印的培养皿放进温度为37摄氏度的恒温箱里
图片尺寸690x649
小豆的手部细菌培养
图片尺寸640x480
洗手可有效减少手部污染, 肥皂或皂液洗手30秒,手部细菌可减少
图片尺寸633x515
手上这些是细菌培养皿.
图片尺寸1199x1599
你手上的汗液,食物残渣,以及不知从哪里摸到的细菌,和适宜的温度加
图片尺寸1080x608
戴着手套的手在培养皿中生长的细菌照片
图片尺寸450x300
手部细菌培养皿实验结果图因此,正确七步洗手法要get哦:齐主任表示
图片尺寸960x280
人手掌上的放大镜和细菌在放大镜下的细菌微生物培养皿的矢量图解多彩
图片尺寸272x300
下面就是在培养皿中对前后采集到的细菌分别进行培养.
图片尺寸640x478
的叔叔阿姨带回实验室"培养",将洗手前后的细菌对比图展示给小朋友们
图片尺寸1080x810
可细菌培养结果真是吓人一跳
图片尺寸479x360
这周陪娃观察了她手指上细菌的生长在培养皿上按了两个手印,第二天啥
图片尺寸1080x1080